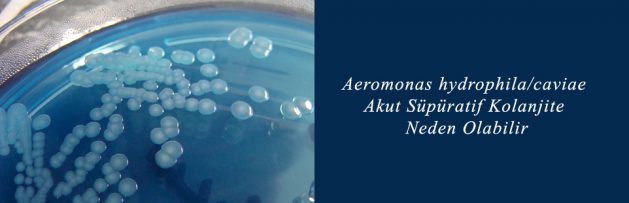

Aeromonas hydrophila/caviae Akut Süpüratif Kolanjite Neden Olabilir
Klimik Dergisi 2016; 29(1): 36-8.
İrvem ve arkadaşları, Klimik Dergisi’nin Nisan 2016 sayısında, safra yollarında inoperabl olarak değerlendirilen malign tümör nedeniyle izlenen 79 yaşındaki bir hastada A. hydrophila/caviae’nın neden olduğu bir süpüratif kolanjit olgusu sunuyorlar. A. hydrophila/caviae suşunun karbapeneme dirençli olduğu da bulunmuş. Taş oluşumuna bağlı olarak safra drenajı bozulmuş ya da malignitesi olan hastalar süpüratif kolanjit açısından özellikle risk altında bulunuyor. Sepsis tablosuyla kaybedilen bu olgu, immünosüprese bireylerdeki hepatobiliyer infeksiyonlarda, Aeromonas tür
Makale İçin [Tıklayınız]
“Karbapeneme Dirençli Aeromonas hydrophila/caviae ile Oluşan Akut Süpüratif Kolanjit Olgusu”
DOI: 10.5152/kd.2016.08